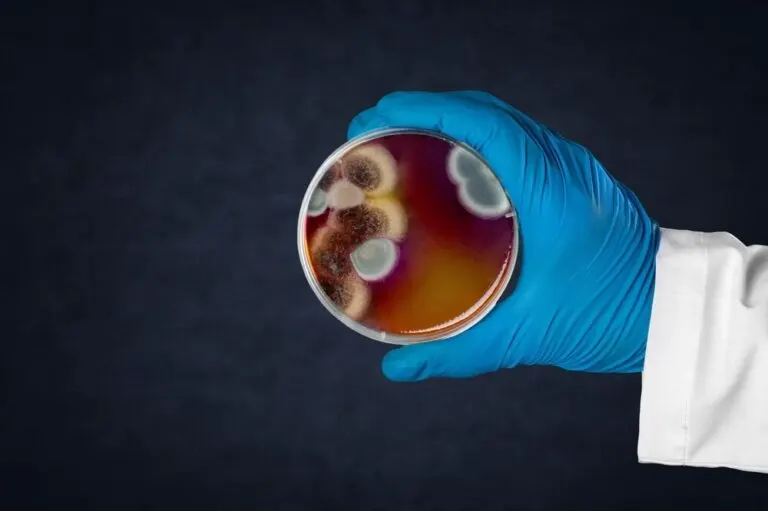

Antimicrobianos: ¿para qué sirven?

Revisado y aprobado por la farmacéutica Sara Viruega
Los antimicrobianos son fármacos que tienen la capacidad de detener o inhibir el crecimiento de diferentes microorganismos. Dependiendo del tipo de microorganismo del que se trate, serán eficaces unos u otros. En este sentido, podemos encontrar diferentes antimicrobianos efectivos frente a bacterias, hongos o parásitos.
A lo largo del artículo veremos para que sirven los distintos tipos de antimicrobianos y cuáles son sus características principales.
Tipo de antimicrobianos

Estos fármacos se pueden clasificar basándose en dos aspectos:
- El mecanismo de acción.
- El tipo de microbio.
Clasificación de los antimicrobianos según su mecanismo de acción
A partir de esta primera clasificación según el mecanismo de acción, se pueden diferenciar los siguientes antimicrobianos:
- Esterilizantes.
- Desinfectantes.
- Antisépticos o quimioterápicos.
Esterilizantes
Los agentes esterilizantes son aquellas sustancias que son capaces de producir tanto la muerte como la inactivación total de cualquier tipo de microorganismo. Dos de los esterilizantes más conocidos son el glutaraldehído y el óxido de etileno.
Por otra parte, cabe mencionar que también existen procedimientos físicos como el calor, la filtración y la radiación ionizante que se usan para este fin.
Lee también: Cómo esterilizar los juguetes sexuales de manera correcta
Desinfectantes
El uso de los desinfectantes tiene como fin eliminar los microorganismos de los materiales inertes, debido a los efectos tóxicos que suelen presentar sobre los tejidos vivos. Entre los más utilizados se encuentran el alcohol y los compuestos con yodo como el famoso Betadine.
Es importante diferenciar la esterilización de la desinfección. A diferencia del primer término, los agentes antimicrobianos desinfectantes no son capaces de eliminar a los microorganismos en su totalidad.
Antisépticos o quimioterápicos
Una de las diferencias entre ambas sustancias es que los antisépticos se aplican directamente sobre los tejidos dañados para evitar el crecimiento de los microbios. Por el contrario, los quimioterápicos se administran de forma intravenosa.
Clasificación de los antimicrobianos según el tipo de microbio
A continuación, se clasifican los antimicrobianos según el microbio sobre el que son eficaces. En este sentido, podemos diferenciar los siguientes:
Antibióticos

El término antibiótico hace referencia a sustancias químicas producidas por un ser vivo, o derivados sintético de ellas, que matan o impiden el crecimiento de ciertas clases de microorganismo sensibles.
Como bien indica su nombre, se utilizan para tratar infecciones producidas por bacterias. Son medicamentos que se utilizan tanto en veterinaria como en medicina humana, al igual que los antiparasitarios y los demás antimicrobianos. El objetivo del tratamiento con antibióticos es conseguir la erradicación del microorganismo patógeno.
Finalmente, es importante mencionar que la automedicación con antibióticos supone un serio problema de salud pública. La razón de ello es que las bacterias son capaces de desarrollar mecanismos de resistencia frente a los diferentes mecanismos de acción de los antibacterianos. De esta forma, los tratamientos inicialmente efectivos dejan de hacer efecto y el arsenal terapéutico se ve reducido.
Antifúngicos
También conocidos como antimicóticos, son sustancias que impiden el crecimiento o matan ciertos tipos de hongos.
Al igual que ocurre con el uso de los antibióticos, como hemos explicado, mucha gente se automedica y se ha abusado mucho de estos medicamentos, provocando que los microorganismos desarrollen resistencias frente a los fármacos conocidos actualmente.
Entre algunos de los antimicóticos más conocidos podemos mencionar:
- Itraconazol.
- Posaconazol.
- Fluconazol.
- Voriconazol.
- Caspofungina.
Antiparasitarios
Este tipo de antimicrobianos se utilizan tanto en veterinaria como en medicina humana para combatir infecciones causadas por bacterias y parásitos y para el tratamiento de algunas formas de cáncer.

Los más conocidos son los antihelmínticos y los antiprozoarios. Entre ellos destacamos:
- Albendazol.
- Mebendazol.
- Trimetoprima.
- Paramomicina.
- Metronizadol.
- Ivermectina.
Hoy en día, se está tratando de descubrir otros antiparasitarios que presenten menos efectos adversos y que combatan el desarrollo de las resistencias de los parásitos a los fármacos comerciales.
Descubre: Cómo eliminar los parásitos de tu cuerpo con clavo seco y linaza
Antivirales
Estos fármacos se utilizan para el tratamiento de infecciones víricas. La principal característica es que no son capaces de curar la enfermedad, sino que palían los síntomas de la misma.
De esta forma, consiguen reducir la gravedad de los síntomas y disminuir las probabilidades de sufrir complicaciones. Hay antivirales para cada tipo de virus y solo se administran bajo prescripción médica.
Conclusión
Las sustancias antimicrobianas son capaces de inhibir el crecimiento de diferentes microorganismos o de causar la muerte de los mismos. Se utilizará un tipo u otro dependiendo de la infección concreta y de la situación.
En cuanto a los fármacos antimicrobianos (antibacterianos, antimicóticos, antiparasitarios y antivirales) son medicamentos sujetos a prescripción médica. Por lo tanto, automedicarse con este tipo medicamentos favorece el desarrollo de resistencias por parte de los microbios y, por ende, un descenso de la eficacia de los tratamientos.
Todas las fuentes citadas fueron revisadas a profundidad por nuestro equipo, para asegurar su calidad, confiabilidad, vigencia y validez. La bibliografía de este artículo fue considerada confiable y de precisión académica o científica.
- Melo. (2012). Guia de Antimicrobianos. Hospital Das Clinicas Da Universidade Federal de Goias HC-UFG. https://doi.org/10.1109/CGO.2007.32
- Arias, M. V. B., & De Maio Carrilho, C. M. D. (2012). Resistência antimicrobiana nos animais e no ser humano. Há motivo para preocupação? Semina:Ciencias Agrarias. https://doi.org/10.5433/1679-0359.2012v33n2p775
- Melo, V. V., Duarte, I. D. P., & Soares, A. Q. (2012). Guia Antimicrobianos. Coordenaçao de Farmacia - Hospital das Clinicas da Universidade Federal de Goiás (HC - UFG).
Este texto se ofrece únicamente con propósitos informativos y no reemplaza la consulta con un profesional. Ante dudas, consulta a tu especialista.







